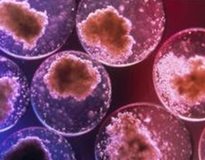

İmmün sistem kendi aşını üretebilir mi?
Yeni aşı mekanizması kronik inflamasyonu önlüyor
 Kopenhag Üniversitesi Biyoteknoloji Araştırma ve İnovasyon Merkezi (BRIC) araştırmacıları, insan vücudunun immün sistemi güçlendirecek ve kronik inflamatuvar hastalıkları önleyebilecek kendi aşısını yaratabildiğini keşfetti. Çalışmaya göre, bu protein aşı olarak vücuda enjekte edildiğinde, multipl skleroz, romatoid artrit ve alerjik astım gibi çok sayıda farklı inflamatuvar hastalığı önleyebiliyor.
Kopenhag Üniversitesi Biyoteknoloji Araştırma ve İnovasyon Merkezi (BRIC) araştırmacıları, insan vücudunun immün sistemi güçlendirecek ve kronik inflamatuvar hastalıkları önleyebilecek kendi aşısını yaratabildiğini keşfetti. Çalışmaya göre, bu protein aşı olarak vücuda enjekte edildiğinde, multipl skleroz, romatoid artrit ve alerjik astım gibi çok sayıda farklı inflamatuvar hastalığı önleyebiliyor.
BRIC araştırmacıları, vücutta bulunan ve kronik doku inflamasyonuna karşı koruyucu olan bir protein keşfetti. Bu protein aşı olarak vücuda enjekte edildiğinde, multipl skleroz, romatoid artrit ve alerjik astım gibi çok sayıda hastalığı önleyebiliyor ve tedavi edebiliyor. Çalışma, Journal of Clinical Investigation’da “Farelerde CD1d ile sınırlı NKT hücrelerinin endojen kolajen peptid aktivasyonu çoklu doku spesifik inflamasyonunu iyileştiriyor” başlığı altında yayımlandı.
 Çalışmanın baş araştırmacısı ve BRIC’de Nöroinflamasyon Birimi Başkanı Prof. Dr. Shohreh Issazadeh-Navikas, çalışmanın Danimarka, İsveç ve Almanya’nın işbirliği ile yürütüldüğünü ve inflamasyon ve inflamatuvar hastalıklar ile savaşmak için yaklaşık on yıllık bir süreçten geçildiğini belirtti. Dr. Issazadeh-Navikas, bulguların inflamasyon ve otoimmünite için önemli olduğunu ve bu proteinin birçok hastalığın tedavisinde kullanılabileceğini açıkladı.
Çalışmanın baş araştırmacısı ve BRIC’de Nöroinflamasyon Birimi Başkanı Prof. Dr. Shohreh Issazadeh-Navikas, çalışmanın Danimarka, İsveç ve Almanya’nın işbirliği ile yürütüldüğünü ve inflamasyon ve inflamatuvar hastalıklar ile savaşmak için yaklaşık on yıllık bir süreçten geçildiğini belirtti. Dr. Issazadeh-Navikas, bulguların inflamasyon ve otoimmünite için önemli olduğunu ve bu proteinin birçok hastalığın tedavisinde kullanılabileceğini açıkladı.
Birçok inflamatuvar ve otoimmün hastalık kronik olmakla birlikte, çok sayıda kişiyi etkiler. Alzheimer, Parkinson, romatoid artrit, alerjik astım, multipl skleroz, tip 2 diyabet ve kanser gibi hastalıklarda inflamatuvar faktörler rol oynar. Araştırmacılar tarafından geliştirilen aşı, NKT hücreleri denilen ve immün sistemde yer alan spesifik hücrelerin sayısını artırıyor.
NKT hücreleri, T hücrelerinin bir çeşididir. Otoimmüniteden patojenlere karşı verilen yanıta kadar birçok süreçte rol oynar. Yaklaşık 20 yıldır, bu hücrelerin CD1 molekülleri tarafından sunulan lipid antijenler ile aktive olduğu düşünülmektedir. Ancak Dr. Issazadeh-Navikas ve ekibi, deneysel otoimmün hastalıklar dahil doku-spesifik inflamatuvar hastalıkları baskılamak için peptidin NKT hücrelerini aktive edebildiğini bizlere göstermiş oldu. Bu epey önemli ve yeni bulgu, sağlıkta ve hastalıkta vücudun inflamasyonla savaşması için yeni bir bakış açısı sundu. Araştırmacılar, NKT hücrelerinin aktive olması için gereken özellikleri de belirledi. Dr. Issazadeh-Navikas, bu verilerin insan homeostazisinin devamı ve inflamasyonun azalması için bu hücrelerin oynadığı fizyolojik rolleri yeni bir bakış açısı getirdiğini vurguladı.
NKT hücreleri, T hücrelerinin bir çeşididir. Otoimmüniteden patojenlere karşı verilen yanıta kadar birçok süreçte rol oynar. Yaklaşık 20 yıldır, bu hücrelerin CD1 molekülleri tarafından sunulan lipid antijenler ile aktive olduğu düşünülmektedir. Ancak Dr. Issazadeh-Navikas ve ekibi, deneysel otoimmün hastalıklar dahil doku-spesifik inflamatuvar hastalıkları baskılamak için peptidin NKT hücrelerini aktive edebildiğini bizlere göstermiş oldu. Bu epey önemli ve yeni bulgu, sağlıkta ve hastalıkta vücudun inflamasyonla savaşması için yeni bir bakış açısı sundu. Araştırmacılar, NKT hücrelerinin aktive olması için gereken özellikleri de belirledi. Dr. Issazadeh-Navikas, bu verilerin insan homeostazisinin devamı ve inflamasyonun azalması için bu hücrelerin oynadığı fizyolojik rolleri yeni bir bakış açısı getirdiğini vurguladı.
 Çalışma sonuçları, otoimmünite, antijen sunumu ve NKT hücreleri alanında yenilik yaratacağa benziyor. Elde edilen veriler, bu hücrelerin biyolojisine ve hastalıklarda oynadıkları rollere ilişkin mekanik bir derinlik sağlayacak ve hastalıkların tedavisine yeni bir bakış açısı kazandıracak.
Çalışma sonuçları, otoimmünite, antijen sunumu ve NKT hücreleri alanında yenilik yaratacağa benziyor. Elde edilen veriler, bu hücrelerin biyolojisine ve hastalıklarda oynadıkları rollere ilişkin mekanik bir derinlik sağlayacak ve hastalıkların tedavisine yeni bir bakış açısı kazandıracak.
KAYNAK: Yawei Liu, Anna Teige, Emma Mondoc, Saleh Ibrahim, Rikard Holmdahl, and Shohreh Issazadeh-Navikas. Endogenous collagen peptide activation of CD1d-restricted NKT cells ameliorates multiple tissue-specific inflammation in mice. Journal of Clinical Investigation, December 13, 2010 DOI: 10.1172/JCI43964
YAZIYI PAYLAŞ


 Alerjik astım belirtileri nelerdir? Astım ve alerji nasıl tedavi edilir?
Alerjik astım belirtileri nelerdir? Astım ve alerji nasıl tedavi edilir? Romatoid artrit nedir? Nedenleri, belirtileri ve tedavi yöntemleri
Romatoid artrit nedir? Nedenleri, belirtileri ve tedavi yöntemleri Alerji nedir, kimlerde görülür? Belirtileri, testi ve tedavisi
Alerji nedir, kimlerde görülür? Belirtileri, testi ve tedavisi Multipl Skleroz (MS) hastalığı neden olur? Belirtileri ve tedavisi
Multipl Skleroz (MS) hastalığı neden olur? Belirtileri ve tedavisi Astımın belirtileri nelerdir? Tanı ve tedavisinde öncelikli hedefler?
Astımın belirtileri nelerdir? Tanı ve tedavisinde öncelikli hedefler?
YORUMUNUZ VAR MI?